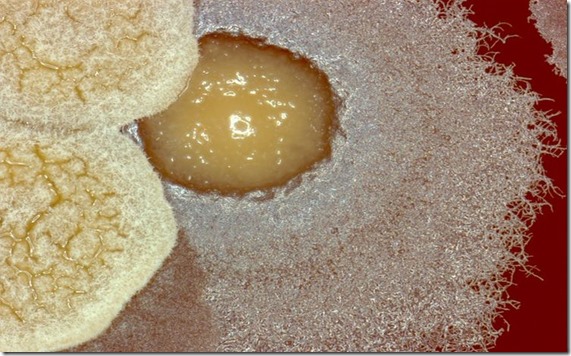

Estas Bacterias son las causantes de Muchas Enfermedades – Lo Peligroso es que se Encuentra en Muchas de Nuestras Comidas
En nuestra cotidianidad es normal que disfrutemos de manjares de la comida. Sin embargo, en nuestro mundo habitan diferentes seres microscópicos llamados Bacterias que nos pueden causar desde un simple malestar hasta la muerte.
Las bacterias son microorganismo que se presentan en diferentes formas y tamaños, muchas de estas atacan el organismo causándole serios problemas de salud.
No todas las bacterias causan enfermedades en el ser humano, de todas la que se han registrado un poco más de 500 son dañinas. De todas formas estos microorganismos son los causantes de la gran mayoría de enfermedades y muertes en la humanidad.
Estos bichos causan desde infecciones serias como la tuberculosis hasta intoxicaciones alimentarias.
La Causante de la infección
Entre este grupo de bacterias encontramos una en particular, la Campylobacter que se relaciona directamente con los alimentos. Esta produce campilobacteriosis, que es un enfermedad infecciosa terrible. Todo comienza con un proceso de incubación que dura aproximadamente 5 días presentando diversos síntomas, entre los que encontramos dolor abdominal, fiebre y diarrea.
El contagio de esta infección bacteriana se puede dar por el contacto directo con los alimentos o agua contaminada, por contacto entre humanos o por contacto con animales infectados.
Habitualmente las mayores transmisoras de esta enfermedad son las aves infectadas. En la mayoría de seres humanos infectados los síntomas son mínimos por eso se suele confundir con otras enfermedades. Sin embargo, se debe tener en cuenta fiebres acompañadas de nauseas, dolor abdominal agudo, espasmos y diarrea.
Sin un tratamiento adecuado la bacteria se puede propagar a través de la sangre causando una septicemia que puede ocasionar hasta la muerte.
En vista de los riesgos que se pueden tener al ingerir diferentes tipos de alimentos, debes estar atento de sus procedencia y el manejo adecuado en el hogar, muchas veces se acostumbra a dejar los alimentos a la intemperie o se dejan solo en el microondas para recalentar, esto puede aumentar seriamente el contagio de esta infecciosa bacteria.
Lo adecuado es dejar los alimentos bien cocidos pues el calor es la clave para eliminar a todas estas alimañas.